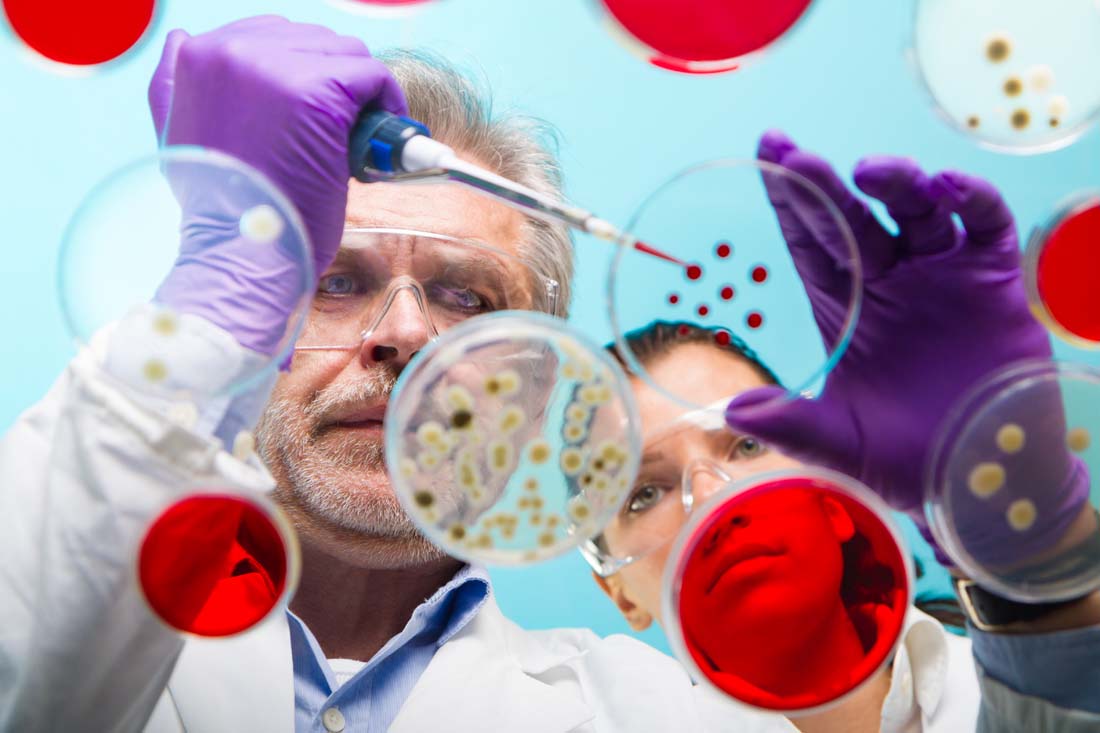
枸櫞酸西地那非片規格，枸櫞酸西地那非片成份

金戈都有哪些成分,對陽痿的治療有效嗎?
金戈是男人的一大福音,陽痿給男人帶來了許多的尷尬,房事不利,勃起障礙,常常被人稱為性無力,金戈在治療陽痿有好的效果,其成分大多是中藥物質,是對男性的腎有好處的物質,提高勃起功能障礙的患者性交能力和成功率。
對大多數患者,推薦使用的量為50mg,按照需要在性活動前約1小時服用;但在性活動前0.5~4小時內的任何時候服用均可。基于藥效和耐受性,劑量可增加至100mg(最大推薦劑量)或降低至25mg。每日最多服用1次。在沒有性刺激時,推薦劑量的西地那非不起作用。
金戈的特點:主要針對三個月以上的性交時陰莖不能勃起,金戈素有國產偉哥的美譽,通過放松血管,而且能夠增加陰莖血液流量,可顯著提高各種ED患者的性交成功率。腎寶片純中藥配方,22種中藥溫陽補腎,調和陰陽,扶正固本。治療腎虧早衰,腰膝酸軟,房事早泄,勃起無力。單獨使用短時間內起效慢。此方案用于所有陽痿患者,無論是輕度、中度或中度陽痿。中西藥結合,把你透支的腎補起來。
通用名稱:枸櫞酸西地那非片
商品名稱:金戈枸櫞酸西地那非片
成份:枸櫞酸西地那非。
性狀:本品為片劑。
適應癥:適用于治療勃起功能障礙。
規格:50mg×1片
藥理作用
本品是治療勃起功能障礙的口服藥物。它是西地那非的枸櫞酸鹽,一種環磷酸鳥苷(cGMP)特異的5型磷酸二酯酶(PDE5)的選擇性抑制劑。
貯藏:密封,30℃以下保存.
包裝:1s/盒。
有效期:18個月.
批準文號:國藥準字H20143255.
生產企業:廣州白云山制藥股份有限公司廣州.
劑型:片劑.
云開亞美大藥房溫馨提醒,為了您的健康,請在您的主治醫生或指導藥師的指導下按療程服用,同時密切接受隨訪,以便他們第一時間了解到您的用藥情況。如在用藥過程有任何不良反應或疑惑,亦可第一時間向云開藥網在線專業藥師咨詢,熱線電話: 400-820-2755。
以上的內容僅是參考,由于藥物的使用以及病情的不同性,在使用藥物之前可以登錄云開藥網,這里我們有專業的藥師為您解答。